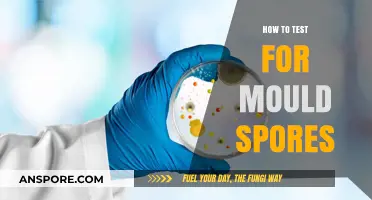
Effective Methods to Test for Mould Spores in Your Home

Understanding how to interpret T-scores in spore analysis is crucial for accurately assessing spore viability and germination potential. T-scores, derived from tetrazolium tests, provide a quantitative measure of metabolic activity within spores, indicating their ability to germinate and grow. This method involves staining spores with a tetrazolium salt, which is reduced by active enzymes in viable spores, producing a colored compound. By measuring the intensity of this color, typically through spectrophotometry, researchers can calculate a T-score that correlates with spore viability. Proper interpretation of T-scores requires standardized protocols, consideration of spore type, and awareness of potential limitations, such as false positives or negatives. Mastering this technique ensures reliable results in fields like microbiology, agriculture, and food safety, where spore viability is a critical parameter.
| Characteristics | Values |
|---|---|
| T-Score Range | -1.0 to +1.0 (standardized scale) |
| Optimal T-Score | Close to 0 (indicating a balanced spore) |
| Positive T-Score | Indicates a heavier spore (e.g., +1.0 is extremely heavy) |
| Negative T-Score | Indicates a lighter spore (e.g., -1.0 is extremely light) |
| Measurement Method | Typically calculated using spore size, shape, and density |
| Common Tools | Microscope, image analysis software, or specialized spore measurement devices |
| Species Variation | T-scores vary by species; reference values are species-specific |
| Environmental Impact | T-scores can be influenced by environmental conditions (e.g., humidity, temperature) |
| Application | Used in taxonomy, ecology, and forensic science for spore identification |
| Latest Research | Advances in AI and machine learning improve T-score accuracy and automation |
What You'll Learn
- Understanding T-Scores: Definition, purpose, and basic interpretation of T-Scores in statistical analysis
- Calculating T-Scores: Formula, steps, and tools for computing T-Scores from raw data
- Interpreting Results: How to analyze T-Score values and their significance in research
- T-Score vs. Z-Score: Key differences and when to use T-Scores over Z-Scores
- Applications in Research: Practical uses of T-Scores in psychology, education, and other fields

Understanding T-Scores: Definition, purpose, and basic interpretation of T-Scores in statistical analysis
T-scores are a standardized measurement used in statistics to simplify the interpretation of raw data by transforming it into a common scale. Derived from the z-score, a T-score is calculated using the formula: T = (X - μ) / σ, where X is the raw score, μ is the population mean, and σ is the population standard deviation. However, T-scores are often adjusted to have a mean of 50 and a standard deviation of 10, making them particularly useful in fields like psychology, education, and medicine. For instance, in bone density tests, a T-score of -1 to -2.5 indicates osteopenia, while below -2.5 signifies osteoporosis. This standardization allows for consistent comparison across different datasets or populations.
The primary purpose of T-scores is to provide a normalized scale that facilitates interpretation and comparison. Unlike raw scores, which vary widely depending on the context, T-scores offer a universal reference point. For example, in educational testing, a T-score of 60 might represent above-average performance, while 40 indicates below-average. This standardization is particularly valuable when comparing individuals from different age groups or testing conditions. However, it’s crucial to understand the specific mean and standard deviation used for normalization, as these values can differ across applications. Misinterpreting the scale can lead to incorrect conclusions, so always verify the reference values for the specific test or dataset.
Interpreting T-scores requires a basic understanding of their distribution and context. A T-score of 50 is average, with every 10-point increase or decrease representing one standard deviation from the mean. For instance, a T-score of 60 is one standard deviation above the mean, while 40 is one below. In practical terms, this means that a score of 60 is significantly higher than average, whereas 40 is notably lower. However, the implications of these scores depend on the field. In bone density, a T-score of 60 is unrealistic, as it would indicate extremely high bone mass, while in cognitive testing, it might signify exceptional ability. Always consider the normative data and clinical relevance when interpreting T-scores.
To effectively use T-scores, follow these steps: 1) Identify the mean and standard deviation used for normalization, as these values dictate the scale. 2) Calculate the T-score using the raw data and the provided formula. 3) Compare the result to established norms or thresholds for the specific application. For example, in psychological assessments, a T-score above 60 might indicate a need for further evaluation, while in medical testing, scores below certain thresholds trigger specific interventions. Caution: Avoid comparing T-scores across different tests or fields unless they use the same normalization parameters. Finally, communicate results clearly, explaining the scale and its implications to avoid misinterpretation. By mastering these steps, T-scores become a powerful tool for meaningful statistical analysis.
Master Spore Mod Installation: A Step-by-Step Origin Guide
You may want to see also

Calculating T-Scores: Formula, steps, and tools for computing T-Scores from raw data
T-scores are a standardized measure often used in statistics to compare an individual's performance to a normative sample. They are particularly useful in psychological testing, medical diagnostics, and educational assessments. To calculate a T-score from raw data, you need to follow a specific formula that transforms raw scores into a standardized scale with a mean of 50 and a standard deviation of 10. This transformation allows for easier interpretation and comparison across different datasets.
The formula for calculating a T-score is: T = (X - μ) / σ * 10 + 50, where X is the raw score, μ is the mean of the raw scores, and σ is the standard deviation of the raw scores. This formula adjusts the raw data to fit the T-score scale, making it possible to compare results from different tests or populations. For example, if a student scores 85 on a test with a mean of 70 and a standard deviation of 15, the T-score would be calculated as (85 - 70) / 15 * 10 + 50 = 61.7. This indicates the student performed above average relative to the normative sample.
When computing T-scores, it’s crucial to ensure the raw data is accurate and the normative sample is representative of the population being tested. For instance, in medical diagnostics, T-scores are used to assess bone density, where a T-score of -1 or above is considered normal, -1 to -2.5 indicates osteopenia, and -2.5 or below signifies osteoporosis. Misinterpreting these values can lead to incorrect diagnoses, so precision in calculation is essential. Always verify the mean and standard deviation values for the specific test or dataset you’re working with.
Several tools can simplify the process of calculating T-scores, especially for those without a strong statistical background. Spreadsheet software like Microsoft Excel or Google Sheets allows you to input raw data and apply the T-score formula using built-in functions. For example, you can use the `=(A1-B1)/C1*10+50` formula, where A1 is the raw score, B1 is the mean, and C1 is the standard deviation. Online calculators and statistical software like SPSS or R also provide automated solutions for T-score conversion, reducing the risk of manual errors.
In practical applications, understanding T-scores can empower individuals to interpret test results more effectively. For instance, parents analyzing their child’s standardized test scores or patients reviewing bone density scans can use T-scores to gauge performance relative to peers or norms. However, it’s important to remember that T-scores are just one metric and should be considered alongside other factors, such as individual progress or clinical context. By mastering the calculation and interpretation of T-scores, you can make more informed decisions based on standardized data.
Hand Sanitizer vs. Ringworm Spores: Does It Effectively Kill Them?
You may want to see also

Interpreting Results: How to analyze T-Score values and their significance in research
T-scores are a standardized metric used to compare an individual’s performance on a test to a normative sample, with a mean of 50 and a standard deviation of 10. In research, understanding how to interpret these values is critical for drawing meaningful conclusions. For instance, a T-score of 60 indicates performance one standard deviation above the mean, suggesting above-average results, while a score of 40 signifies below-average performance. This standardization allows researchers to compare data across different studies, populations, or time points, ensuring consistency and reliability in analysis.
When analyzing T-scores, context is key. A score of 70, two standard deviations above the mean, may indicate exceptional performance in cognitive assessments but could be a red flag in bone density tests, where it suggests osteoporosis. Researchers must consider the specific domain being measured and the normative sample used for standardization. For example, in pediatric research, age-specific norms are essential, as a T-score of 55 for a 10-year-old may differ in significance from the same score in a 16-year-old due to developmental variations.
Practical steps for interpreting T-scores include identifying the reference group, understanding the scale’s directionality (higher scores may indicate better or worse outcomes depending on the measure), and calculating effect sizes to quantify the magnitude of differences. For instance, a T-score difference of 10 points between two groups in a clinical trial could represent a moderate to large effect, depending on the context. Caution should be exercised when generalizing results, as T-scores are relative to the normative sample and may not apply universally.
In research, T-scores are often used in conjunction with other statistical tools, such as confidence intervals or p-values, to strengthen interpretations. For example, a T-score difference of 8 points between experimental and control groups, paired with a p-value of 0.01, provides robust evidence of a statistically significant effect. However, researchers should avoid over-relying on T-scores alone, as they do not account for factors like test reliability or external validity.
Ultimately, the significance of T-scores lies in their ability to standardize and contextualize data, making them a valuable tool in research. By carefully considering the normative sample, domain-specific implications, and complementary statistical methods, researchers can leverage T-scores to draw accurate, actionable insights. Whether assessing cognitive abilities, bone health, or other metrics, mastering T-score interpretation enhances the rigor and applicability of research findings.
Bryophytes: Understanding Their Reproduction Through Spores, Not Seeds
You may want to see also

T-Score vs. Z-Score: Key differences and when to use T-Scores over Z-Scores
In statistical analysis, the choice between T-Scores and Z-Scores hinges on the availability of population parameters. T-Scores are calculated when the population standard deviation is unknown, relying instead on the sample standard deviation. This makes them ideal for smaller datasets or situations where population data is inaccessible. Conversely, Z-Scores require knowledge of both the population mean and standard deviation, rendering them more precise but less flexible in real-world applications. Understanding this distinction is crucial for accurate data interpretation.
Consider a scenario where a researcher is studying the bone density of a new dietary supplement’s users. With only a small sample of participants and no access to broader population data, a T-Score becomes the appropriate choice. The formula for a T-Score is: T = (X - μ) / (s / √n), where *X* is the sample mean, *μ* is the population mean, *s* is the sample standard deviation, and *n* is the sample size. For instance, if a participant’s bone density is 1.2 units above the sample mean, with a sample standard deviation of 0.5 and a sample size of 30, the T-Score would be 2.4. This value can then be compared to T-distribution tables to determine statistical significance.
While Z-Scores offer a standardized measure of how many standard deviations a data point lies from the mean, their utility is limited without complete population data. The formula Z = (X - μ) / σ requires the population standard deviation (*σ*), which is often unavailable in practical research. For example, if a clinician assesses a patient’s bone density using a Z-Score, they would need the exact standard deviation of the entire population—a rare luxury. In contrast, T-Scores adapt to sample-based estimates, making them more versatile for preliminary studies or niche populations.
When deciding between T-Scores and Z-Scores, consider the sample size and data availability. For samples under 30, T-Scores are generally preferred due to their robustness with smaller datasets. However, as sample size increases, the T-distribution approximates the Z-distribution, reducing the difference between the two. Practical tip: Always verify the assumptions underlying each score. For instance, T-Scores assume data normality, so perform a Shapiro-Wilk test if unsure. By tailoring your choice to the context, you ensure statistical rigor and meaningful insights.
Do Carnivorous Plants Produce Spores? Unraveling the Myth and Facts
You may want to see also

Applications in Research: Practical uses of T-Scores in psychology, education, and other fields
T-scores, a standardized measurement in statistics, transform raw data into a uniform scale with a mean of 50 and a standard deviation of 10. This standardization facilitates comparisons across diverse datasets, making T-scores invaluable in research. In psychology, for instance, T-scores are used to interpret results from personality assessments like the Minnesota Multiphasic Personality Inventory (MMPI). A T-score of 65 or above on the MMPI’s depression scale might indicate clinically significant depressive symptoms, while scores below 45 suggest below-average levels. This clear threshold helps clinicians make informed diagnoses and treatment plans.
In education, T-scores play a pivotal role in standardizing test results, ensuring fairness across different exams or schools. For example, the Wechsler Intelligence Scale for Children (WISC) uses T-scores to report IQ subtest results. A T-score of 60 on the verbal comprehension index corresponds to the 84th percentile, indicating above-average performance. Educators use these scores to identify learning strengths and weaknesses, tailoring interventions for students. However, interpreting T-scores requires caution; they should be contextualized with other data to avoid oversimplification of a student’s abilities.
Beyond psychology and education, T-scores find applications in fields like medicine and sociology. In medical research, T-scores are used to assess bone density, with a score below -2.5 indicating osteoporosis. This standardized measure allows healthcare providers to compare patient results across different testing facilities. In sociology, T-scores help analyze survey data, enabling researchers to identify trends in attitudes or behaviors. For instance, a study on environmental awareness might use T-scores to rank respondents’ eco-friendly practices, with higher scores reflecting greater sustainability efforts.
To effectively use T-scores in research, follow these steps: first, ensure the raw data is normally distributed, as T-scores assume a bell-curve distribution. Second, apply the formula: T = (X - μ) / σ * 10 + 50, where X is the raw score, μ is the mean, and σ is the standard deviation. Third, interpret the results within the context of the specific assessment or study. For example, in a study on stress levels among college students, a T-score of 70 might indicate high stress, warranting further investigation. Always consider the limitations of T-scores, such as their reliance on group norms, and supplement them with qualitative data for a comprehensive analysis.
Embracing Freedom: A Guide to Unapologetic Self-Expression in Singapore
You may want to see also
Frequently asked questions
A T-score in spore testing is a statistical value used to determine the viability of spores after exposure to sterilization processes. It is important because it helps assess the effectiveness of sterilization methods by comparing the number of surviving spores to a control group, ensuring safety and compliance with standards.
The T-score is calculated using the formula: T = (Number of Surviving Spores / Control Count) × 100. This percentage indicates the spore kill rate, with a lower T-score suggesting higher sterilization efficacy.
A passing T-score typically requires a spore kill rate of ≥99.9999% (6-log reduction) for most sterilization processes. This ensures that the method is effective in eliminating spores and meets regulatory requirements.